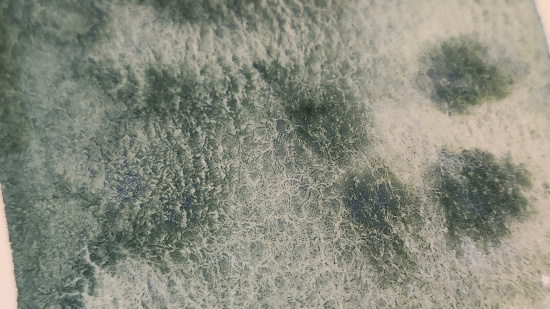

Описание
Пятнадцать новых цветов: аквамариновая дымка, гематитовая дымка, голубая дымка, голубая мгла, зеленая мгла, кобальтовая дымка, лазурная мгла, серо-розовая дымка, серо-синяя дымка, синяя мгла, сиреневая дымка, таежная дымка, фиолетовая дымка, фиолетовая мгла, хром-кобальтовая дымка. Краски на основе чёрного пигмента PBk11 объединены названием «мгла». Краски «дымка» это композиции разных пигментов с сильной грануляцией. Наименования «мгла» и «дымка» позволяют по названию отделить краски с сильной грануляцией от других оттенков в палитре.
¶Благодаря крупным частицам пигментов в процессе работы краски растекаются неравномерно и распадаются на оттенки! Усиливая эффект от фактуры поверхности бумаги, позволяют создать заливки с сильной грануляцией. В зависимости от толщины красочного слоя, объёма воды и движения кисти можно получить абсолютно разные текстуры, точно передав глубину, тени, кожу и драпировки.
¶Благодаря крупным частицам пигментов в процессе работы краски растекаются неравномерно и распадаются на оттенки! Усиливая эффект от фактуры поверхности бумаги, позволяют создать заливки с сильной грануляцией. В зависимости от толщины красочного слоя, объёма воды и движения кисти можно получить абсолютно разные текстуры, точно передав глубину, тени, кожу и драпировки.
229 руб.
206.1 руб.
Скидка 10%
В корзину
В избранное
Характеристики
|
Производитель
|
Невская Палитра |
|
Номер
|
563 |
|
Объем
|
10мл |
|
Пигмент
|
PB28, PG17 |
|
Прозрачность
|
SO |
|
Серия
|
Белые ночи |
|
Светостойкость
|
*** |
|
Подкатегория
|
Акварель |
|
Категория
|
Краски |
|
Производитель
|
Невская Палитра |
|
Номер
|
563 |
|
Объем
|
10мл |
|
Пигмент
|
PB28, PG17 |
|
Прозрачность
|
SO |
|
Серия
|
Белые ночи |
|
Светостойкость
|
*** |
|
Подкатегория
|
Акварель |
|
Категория
|
Краски |
Описание
Пятнадцать новых цветов: аквамариновая дымка, гематитовая дымка, голубая дымка, голубая мгла, зеленая мгла, кобальтовая дымка, лазурная мгла, серо-розовая дымка, серо-синяя дымка, синяя мгла, сиреневая дымка, таежная дымка, фиолетовая дымка, фиолетовая мгла, хром-кобальтовая дымка. Краски на основе чёрного пигмента PBk11 объединены названием «мгла». Краски «дымка» это композиции разных пигментов с сильной грануляцией. Наименования «мгла» и «дымка» позволяют по названию отделить краски с сильной грануляцией от других оттенков в палитре.
¶Благодаря крупным частицам пигментов в процессе работы краски растекаются неравномерно и распадаются на оттенки! Усиливая эффект от фактуры поверхности бумаги, позволяют создать заливки с сильной грануляцией. В зависимости от толщины красочного слоя, объёма воды и движения кисти можно получить абсолютно разные текстуры, точно передав глубину, тени, кожу и драпировки.
¶Благодаря крупным частицам пигментов в процессе работы краски растекаются неравномерно и распадаются на оттенки! Усиливая эффект от фактуры поверхности бумаги, позволяют создать заливки с сильной грануляцией. В зависимости от толщины красочного слоя, объёма воды и движения кисти можно получить абсолютно разные текстуры, точно передав глубину, тени, кожу и драпировки.
Характеристики
|
Производитель
|
Невская Палитра |
|
Номер
|
563 |
|
Объем
|
10мл |
|
Пигмент
|
PB28, PG17 |
|
Прозрачность
|
SO |
|
Серия
|
Белые ночи |
|
Светостойкость
|
*** |
|
Подкатегория
|
Акварель |
|
Категория
|
Краски |